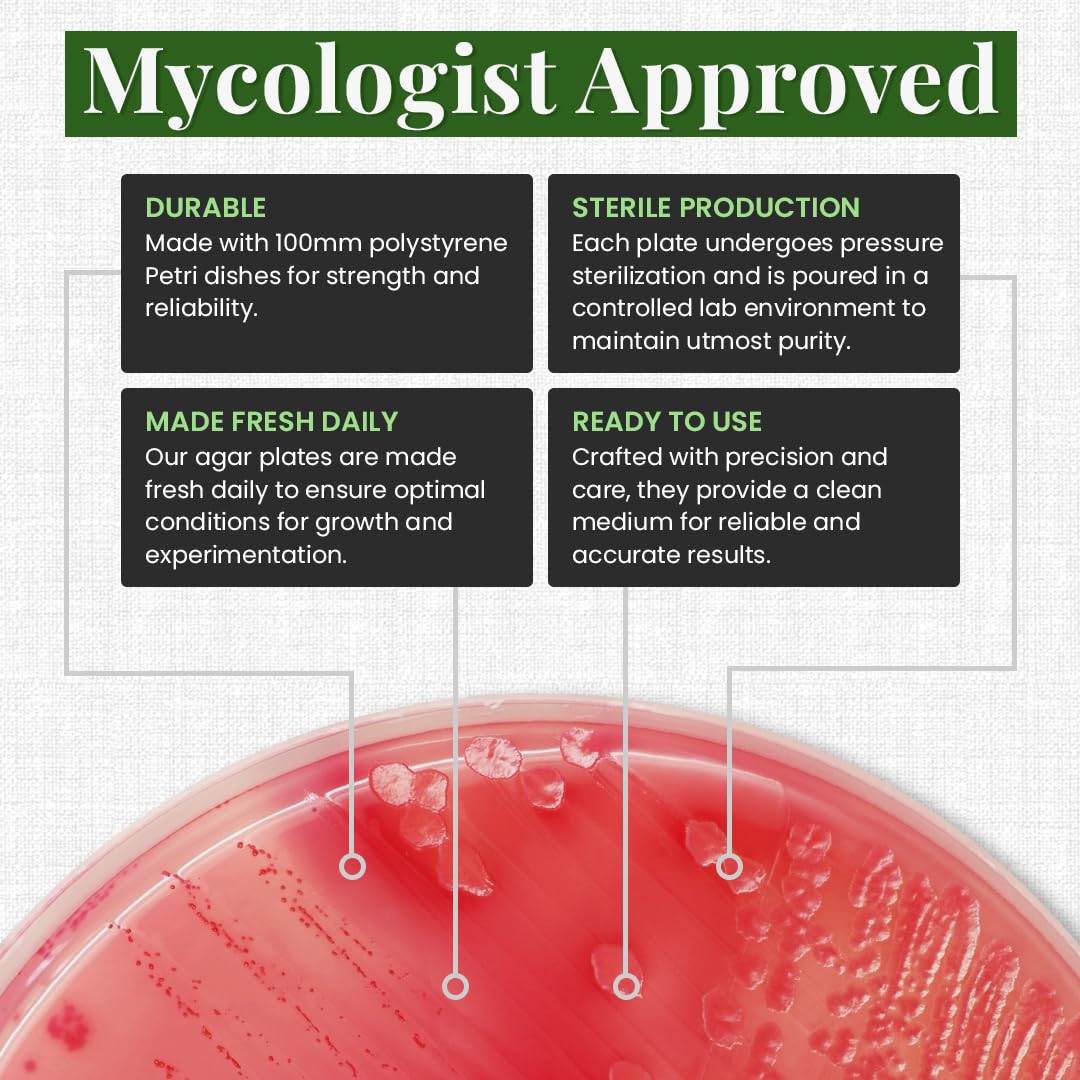
Thumbnail 4

Customer Services
Copyright © 2025 Desertcart Holdings Limited
Desert Online General Trading LLC
Warehouse # 7, 4th Street, Umm Ramool, Dubai, 30183, Dubai

🌟 Unlock Your Mycelium Magic!
Gro Magik's Premium Pre-Made Malt Extract Agar Plates are expertly crafted in a sterile environment, ensuring a nutrient-rich medium ideal for mycology enthusiasts. Each plate is pressure sterilized and sealed for freshness, making them perfect for growing fungal cultures, cloning wild mushrooms, and germinating spores. Enjoy the convenience of ready-to-use plates that support robust mycelium growth.
Trustpilot
1 month ago
2 months ago
5 days ago
3 weeks ago